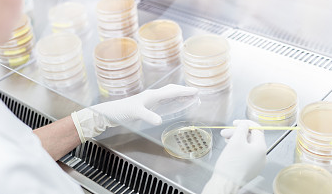

培養(yǎng)基滅菌是一個至關重要的步驟,以確保實驗的無菌條件和數(shù)據(jù)的可靠性。滅菌過程需要考慮多種因素,包括培養(yǎng)基的成分、微生物的耐熱性、pH值、培養(yǎng)基中顆粒的大小、泡沫的存在以及滅菌器內(nèi)空氣的排除情況。
滅菌的方法很多,在實驗室可以使用干熱滅菌、對于環(huán)境可以使用化學試劑滅菌,但化學試劑的滅菌方法有很大的限制。在工業(yè)生產(chǎn)中,對于培養(yǎng)基、管道、設備的滅菌,通常采用蒸汽加熱到一定的溫度,并保溫一段時間的滅菌方法,稱之為濕熱滅菌。
濕熱滅菌的顯著優(yōu)點是:使用方便,無污染,而且其冷凝水可以直接冷凝在培養(yǎng)基中,也可以通過管道排出。培養(yǎng)基滅菌的效果,影響因素很多,除了培養(yǎng)基內(nèi)雜菌的種類和數(shù)量,滅菌溫度的高低,時間長短外,還取決于:
1.營養(yǎng)成分的保持
濕熱滅菌時,微生物被殺死的同時,培養(yǎng)基的營養(yǎng)成分也遭到了一定的破壞,特別是氨基酸和維生素。如在121℃,僅20min,就有59%的賴氨酸和精氨酸及其他堿性氨基酸被破壞,蛋氨酸和色氨酸也有相當數(shù)量被破壞。在熱的作用下某些營養(yǎng)成分還可能因受熱而相互之間發(fā)生反應,造成培養(yǎng)基中原有營養(yǎng)成分的數(shù)量變化,因而影響培養(yǎng)基質(zhì)量。
2.微生物的耐熱性
細菌芽孢的熱阻較大,滅菌所需要的時間取決于把細菌芽孢減少到所規(guī)定數(shù)目的時間。
3.pH值
pH值對微生物的耐熱性影響很大。pH值介于6.0~8.0時,微生物*不易死亡。pH<6.0時,微生物比較容易死亡,此時H+很容易滲入微生物的細胞,從而改變細胞的生理反應,促使其死亡。所以培養(yǎng)基的pH越低,所需的時間也越短。
4.培養(yǎng)基成分
油脂、糖類及蛋白質(zhì)等組成的高濃度有機物會包于細胞的周圍形式一層薄膜、影響熱的傳導。而高濃度的鹽類、色素則削弱其耐熱性,滅菌較易。例如:大腸桿菌在水中加熱至60-65℃便死亡,在10%糖液中需70℃加熱4-6分鐘才死亡,在30%糖液中需30分鐘才死亡。一般糖類含量較多的時候選用115℃,30分鐘;一般的培養(yǎng)基可選擇121℃20分鐘。
5.泡沫
泡沫中的空氣形成隔熱層,使熱量難以滲透進去,殺死其中的雜菌。
6.顆粒
顆粒小,容易滅菌,顆粒大,則難滅菌。對于含有少量較大顆粒及粗纖維的培養(yǎng)基,可用粗濾的方法(不應影響培養(yǎng)基質(zhì)量)予以除去,培養(yǎng)基結(jié)塊會造成培養(yǎng)基滅菌的不*。
7.滅菌鍋內(nèi)空氣是否排凈
這個是影響滅菌是溫度和壓力比例關系的要點,同樣達到了相同的壓力的情況下,如果空氣未能排凈,也就是說不是純蒸汽滅菌,此時的溫度不一定能達到目的要求,會嚴重影響滅菌效果。






